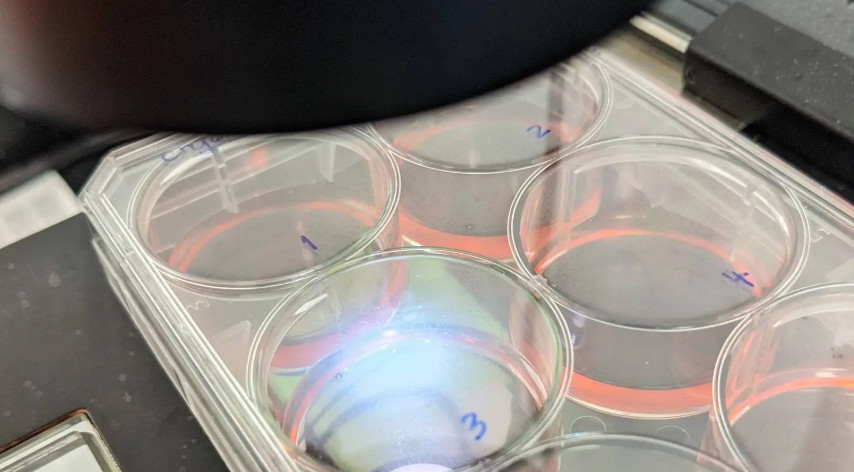
Mayo Clinic's Center for Regenerative Biotherapeutics is collaborating with the biotech firm <a href="/hepatx/">HepaTx</a> on an experimental therapy to regenerate tissue in patients with late-stage #liverdisease. <a href="/MayoClinic/">Mayo Clinic</a> 
mayocl.in/41itXBC

Robert Huebert
@rhuebert
A Father, Husband, Hepatologist, and Skydiver. Director of the Mayo Clinic Enterprise Transplant Research and Innovation Center.
ID: 218302059
21-11-2010 23:52:17
346 Tweet
789 Followers
830 Following












The present study demonstrates lower rates of ischemic cholangiopathy and improved graft survival with NRP alone or NRP + NMP compared with SCS when using #liver grafts from DCD donors. #LiverTransplant Shennen Mao, MD Bashar Aqel Amit K. Mathur, MD MS FACS KrisCroome bit.ly/415zrzc



We are hiring! Looking for ambitious and eager to learn candidates for Research Assistant role to join our fast-paced, multidisciplinary team working on new therapies for liver fibrosis and it’s life-threatening sequelae. Please share! Apply here: bilh.wd1.myworkdayjobs.com/External/job/B…


journals.lww.com/hep/abstract/9… Our work on AI-generated synthetic data for liver transplant research just published in HigherEdPerspectives. Diffusion models can create statistically faithful datasets that maintain clinical correlations while ensuring privacy.



AI is powerful in detecting potential impacts of early interventions to delay or prevent organ failure and the need for organ replacement therapies. Press play to hear more about research efforts to use #AI to detect #organfailure earlier. Rohan Goswami bit.ly/44RlbMy